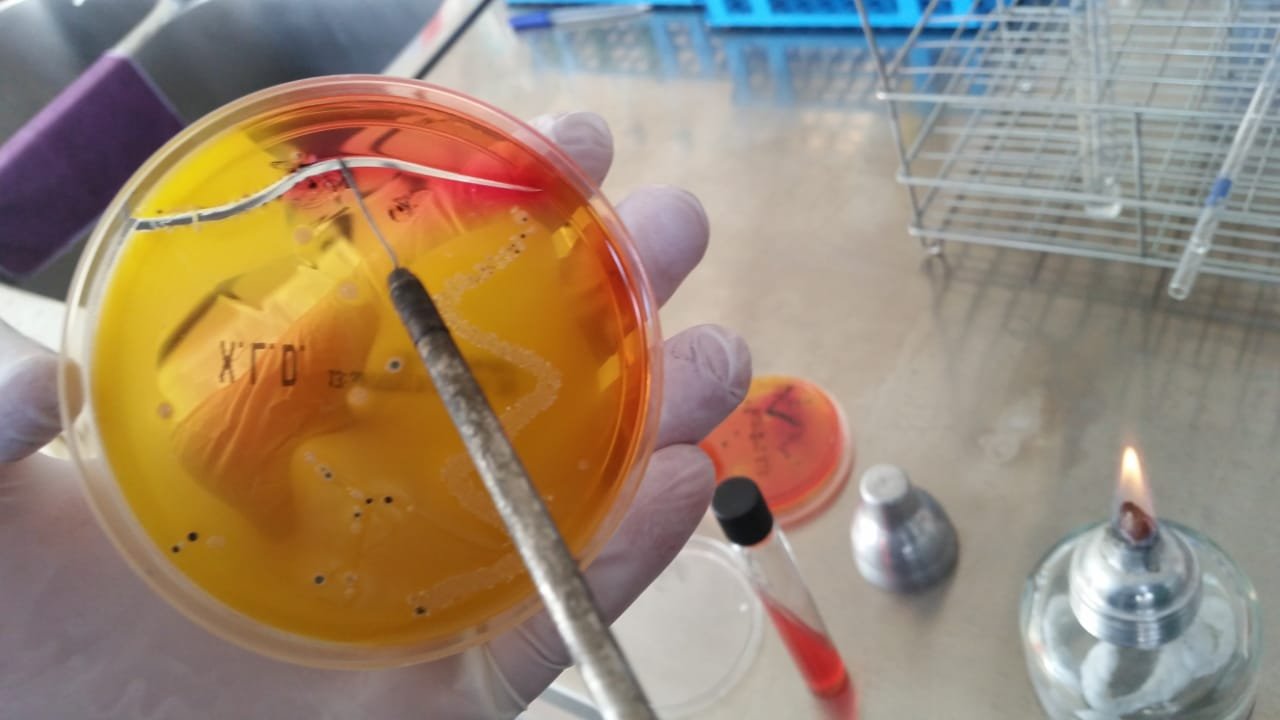

Autor: Mariglen Mërtiri – Qendra Alert
Laboratorët e Autoritetit Kombëtar të Ushqimit që kontrollojnë sigurinë ushqimore në vend janë të amortizuar, të pa akredituar, me stafe të patrajnuar dhe nuk ofrojnë analiza të sakta shkencore në numrin e limituar të analizave që kryejnë.
Bashkimi Europian ka investuar mbi 2 milionë euro për pajisjet laboratorike dhe ato ndihmëse në 3 laboratorë deri në vitin 2019, por pajisjet ose ishin të pa kalibruara, ose nuk vendoseshin në funksion edhe pse ishin marrë në dorëzim, ndërsa trajnimi i stafeve ishte i pamjaftueshëm për pajisjet e reja. Gjatë vitit 2020, për shkak të mungesës së kiteve laboratorike, por edhe stafeve dhe kushteve të punës nuk u realizua numri i mostarve të planifikuara.
Për vitin 2021 nuk parashikohet asnjë investim në laboratorë nga buxheti i shtetit, ndërsa ekspertët e laboratorëve vijojnë të bëjë thirrje për akreditim dhe mbështetje financiare për përmirësimin e situatës në “zemrën” e sigurisë ushqimore, për identifikimin dhe kapjen në kohë të problematikave me ushqimin dhe publikimin e raport-analizave të sakta dhe ligjore.
Përmirësimi i sigurisë ushqimore duhet të kthehet në një prioritet kombëtar, pasi është thelbësor për shëndetin publik dhe zhvillimin ekonomik të vendit. Siguria ushqimore e cenuar dhe mungesa e përmirësimit të saj, përbën jo vetëm një burim të mundshëm për përhapjen e më shumë se 200 sëmundjeve, por ushqimet e ndotura shkaktojnë vdekje çdo vit.
Vendi ynë konsiderohet me incidencë të lartë në këtë fushë referuar të dhënave jo zyrtarë të rasteve të helmimeve nga ushqimi në një vit. Sëmundjet që vijnë nga ushqimi shkaktojnë probleme ekonomike dhe financiare për familjet shqiptare, pasi jovetëm që rrisin shpenzimet për shëndetin, por në të njëjtën kohë, rrisin shpenzimet për ushqim dhe pije joalkolike, duke marrë në konsideratë që shpenzimet për to zënë mesatarisht mbi 50 % në strukturën e buxhetit të familjeve sipas grupeve kryesore të konsumit.

Fuqizimi i institucioneve shtetërore që veprojnë në fushën e sigurisë ushqimore bën të mundur parandalimin dhe zvogëlimin e sëmundshmërisë që vjen nga ushqimi, për më tepër që në mënyrë të vazhdueshme kërkohet zbatimi i politikave evropiane për një nivel të lartë të sigurisë ushqimore për tju afruar kushteve të unionit.
Aktualisht, siguria ushqimore në vend duhet të garantohet në nivel qendror nga Ministria e Bujqësisë dhe Ministria e Shëndetësisë dhe në nivel vendor nga njësitë e pushtetit lokal. Ministria e Bujqësisë ka në strukturë Drejtorinë e Politikave të Sigurisë Ushqimore dhe Mbrojtjes së Konsumatorit, Institutin e Sigurisë së Ushqimit dhe Veterinare (ISUV), dhe Autoritetin Kombëtar të Ushqimit (AKU).
Ky i fundit ka një rol parësor në parandalimin e shumë problematikave që ndodhin sot me ushqimin në raport me konsumatorët. Që një institucion të ketë besueshmëri dhe integritet duhet ta demonstrojë atë nëpërmjet burimeve njerëzore dhe investimeve të pandalshme për ngritjen e kapaciteteve infrastrukturore.
Autoriteti Kombëtar i Ushqimit është një institucion 10-vjeçar i krijuar për të garantuar shëndetin e popullatës nga ushqimi. Por, ai përballet me mungesë fondesh dhe pajisjesh, mungojnë trajnimet e vazhdueshme të burimeve njerëzore dhe dëmtohet nga ndërhyrjet e politikës duke shkëputur zinxhirin e nevojshëm kontrollues të sigurisë ushqimore.
AKU sot ka një rrjet laboratorësh në 7 qarqe të vendit nga ku kryhen analiza të kufizuara për të gjetur problematikat dhe parandaluar kontaminimin. Ky rrjet laboratorësh, edhe pse i investuar vitet e fundit nga Bashkimi Europian dhe qeveria shqiptare nuk arrin të jetë produktiv dhe i besueshëm pasi herë mungojnë reagentët, herë intepretuesit e analizave dhe herë kitet laboratorike. Mungojnë kushtet e punës dhe nuk ka mirëmbajtje dhe kalibrime të pajisjeve laboratorike. Ekzistojnë një sërë analizash laboratorike që nuk kryhen në laboratorë duke përfshirë aditivët, alergenet, disa ndotës dhe patogjenë.
Bazuar në Strategjinë Ndërsektoriale për Bujqësinë dhe Zhvillimin Rural për periudhën 2014-2020 nisi edhe investimi “Ristrukturimi dhe forcimi i rrjetit të laboratorëve të sigurisë ushqimore dhe veterinarisë në Shqipëri”. Prej vitit 2013, Bashkimi Europian nëpërmjet projektit “IPA” ka investuar mbi 2 milionë euro vetëm në pajisje laboratorike të shtrirë në disa vite për të plotësuar nevojat e këtij rrjeti dhe rritur sigurinë ushqimore. Pjesë e kësaj mbështetje me një shumë rreth 300 mijë euro ka qenë edhe buxheti i shtetit.
Laboratorët e AKU që morrën mbështetje ishin ato në Korçë, Gjirokatsër dhe Shkodër. Përzgjedhje e këtyre 3 laboratorëve për t’u investuar nuk pati një strategji apo analizë se kush ishin arsyet konkrete që investimi të ishte sa më përfitues për qytetarët.
Referuar një auditimi të bërë nga Kontrolli i Lartë i Shtetit rezultoi se, nga 4 lote prokurimesh të shtrira në disa vite, që do duhet të merrnin laboratorët, u realizuan vetëm 3, pasi një nga tenderat dështoi edhe pse financimi ishte gati. Në faqen zyrtare të Komisionit Evropian u dha ky koment për arsyen e anulimit: “Mungesë fondesh për shkak të skadimit të afatit të kontratës për Programin Kombëtar IPA 2013 gjatë procesit të vlerësimit të Lotit 2 “Testimi Mikrobiologjik”.
Referuar raportit të KLSH, në korrik të 2019 rezulton se, tre pajisjet e Lotit1: Near Infra Red Food multiparamentric analyzer; Near Infra Red Grain Multiparametric Analyser; dhe Near Infra Red Wine and Spirits multiparametric analyser, janë të pakalibruara, për rrjedhojë të papërdorshme për të dhënë një rezultat të saktë laboratorik. Ndërsa dy pajisjet e përfituara nga loti 4, nuk përmbushin ndonjë qëllim për përmirësimin e cilësisë laboratorike në AKU lidhur me mbetjet e pesticideve në DRAKU Shkodër.

Loti 4 IPA
“Pajisjet kanë një periudhë të gjatë kohe në DRAKU përfituese, por dhe nga akti i marrjes së përkohshme në dorëzim, nuk janë kalibruar apo axhustuar për t’u kthyer në aparatura që prodhojnë analiza të sakta dhe të besueshme ligjore”, thuhet në raportin e KLSH në vitin 2019.
Mbi dy milionë eurot e investuara nuk e ndryshuan situatën e laboratorëve dhe nuk prodhuan më shumë siguri për qytetarët. Gama e analizave të kryera me cilësi nuk u rrit për shkak të investimit. Autoriteti Kombëtar i Ushqimit, i pyetur mbi investimin e Bashkimit Europian dhe mundësitë e reja të ofruara për shkak të pajisjeve të investuara, deklaroi se nga ky financim, AKU rajonale perfituan pajisje ku disa prej tyre janë pajisje “screening” që lehtësojnë punën e stafit të laboratorëve. Ndërkohë, puna vazhdon përmes metodikave zyrtare të analizimit dhe metodave të konfirmuara.
Bazuar në gjetjet e raportit auditues të KLSH-së, ekspertët dolën në përfundimin se, nga ky proces i shtrirë në disa vite ka dështuar edhe trajnimi i stafeve të laboratorëve, pasi ato kanë qenë të pakta dhe të përgjithshme.
“Asnjë DRAKU përfituese nuk ka përfituar trajnim nga projekti për pajisjet e testeve të shpejta NIR Analyzer, Milk and Milk Product Analyzer, Florescent microscopic Somatic Cell Counter edhe pse ky ka qenë qëllimi i projektit për Lotin 1. AKU nuk ka qenë pëfitues i asnjë trajnimi për lotin 4 “Mbetjet e Pesticideve”, pasi rolin kryesor për këtë lot e merr ISUV. Temat trajnuese te realizuara deri në momentin e përfundimit të këtij auditi, kanë plotësuar pjesërisht objektivat dhe qëllimin e projektit”, nënvizon raporti.
Raporti i KLSH edhe pse publik me gjetje dhe me rekomandime konkrete. kundërshtohet nga AKU. pasi në përgjigjë të kërkesës për trajtimin e stafeve. ajo deklaron se trajnimet kanë qenë të vazhdueshme.

Auditimi i Kontrollit të Lartë të Shtetit
“Stafi i laboratorëve rajonale ka marrë trajnime në lidhje me funksionimin e pajisjeve gjatë implementimit të kontratave të furnizimit dhe të shërbimit të financuara nga BE.”
Problematikat e theksuara në 7 laboratorët që AKU ka në varësi edhe pse zyrtarisht nuk pranohen, ato konfirmohen nga analiza vjetore e punës bërë për vitin 2020. Sektori i koordinimit dhe mbështetje së laboratorëve në raport evidenton problematikat, që nga pajisja me apartura të reja e deri tek mungesa e stafeve dhe kushteve më minimale të punës. Në analizën vjetore kërkohet akreditimi i laboratorëve dhe mbështetje më e madhe buxhetore për shkak të fokusit të punës që ky sektor ka, garantimin e sigurisë ushqimore.
Raporti Vjetor Agjencia Kombëtare e Ushqimit
“Është e domosdoshme pajisja me aparatura të reja dhe duhet të kryhet dalja jashtë përdorimit të aparaturave, të cilat janë në inventar, por nuk janë në gjëndje pune. Alokim i fondeve me qellim rritjen e kapaciteteve të rrjetit laboratorik dhe zgjerim të gamës së analizave për të kryer monitorime dhe analiza të produkteve ushqimore dhe ushqimit për kafshë, me referencë specifike në fushat e monitorimit të mbetjeve të pesticideve, diagnozës mikrobiologjike në ushqim dhe ushqim për kafshë, standarteve të cilesisë, sëmundjeve të kafshëve, në përputhje me standarte të përmirësuara. Investime në përmirësimin e infrastrukturës së laboratorëve.
Zbatimin e sistemit LIMS (Laboratory Information Management Systems) në laboratorët e AKU. Mbështetje me buxhet të veçantë për nisjen e proçedurave me qëllim akreditimin e laboratorëve të AKU. Trajnime të vazhdueshme stafit laboratorik. Nuk ka mjedis të veçantë të përshtatshëm për asgjësimin e mbetejve të laboratorit te shëndetit të kafsheve; Nuk ka dhoma të posaçme për ruajtjen e reagenteve, si dhe nuk ka dhome të veçantë për grumbullimin e mbetjeve laboratorike”, janë disa nga kërkesat bërë nga ky sektor drejtuar Ministrisë së Bujqësisë.
Vështirësitë e hasura nga stafet e laboratorëve, por edhe nga gjithë zinxhiri ndërlidhës nga marrja e mostrave e deri në analizmin final për vitin 2020, ka sjellë mosrealizmin e mostrave të planifikuara.
“Numri i mostrave të marra nga Inspektorët e Sektorit të Kontrollit në Pikat e Inspektimit Kufitar për vitin 2020 është 2065 mostra, ndërsa numri i mostrave të planifikuara për vitin 2020 ka qenë 3090 mostra. Pra, numri i mostrave të analizuara është 1025 mostra më pak se numri i mostrave të planifikuara.”
Në argumentet e pretenduara për mosrealizmin e planit, përveç ndikimit të vitit pandemik, nga muaji Maj dhe deri muajin Gusht, laboratori i DRAKU Korçë ka pasur mungesë reagentesh dhe mungesë stafi për kryerjen e analizave laboratorike, si dhe mugonin kushtet e mbajtjes së produkteve shtazore në temperaturë pas orës 14:00 në të cilën mbyllet laboratori. Por AKU, këto vështirësi ja atribuon vetëm situatës së Covid-19.
“Viti 2020 ka qenë një vit pandemie dhe ka pasur vështirësi jo për mungesa, por për shkak të fokusimit në planin e punës, sa lidhet me respektimin e masave anti-covid. Sektori i Shërbimeve Laboratorike ka pasur një zhvillim normal të aktivitetit”, deklaron AKU.
Laboratorët edhe pse janë një investim i domosdoshëm dhe emergjent dhe me ndikim direkt tek konsumatorët, për të qenë të besueshëm dhe mbrojtur jetën e tyre, Ministria e Bujqësisë edhe për vitin 2021 nuk parashikon asnjë fond për investime në këtë sektor.
“Në planin e buxhetitte vitit 2021 (në zbatim të ligjit nr.137/2020, datë 16.11.2020 “Për buxhetin e vitit 2021”), nuk ka fond investimesh për laboratorët. Po bashkëpunohet ngushtësisht me organizma ndërkombëtare, diskutime ne proces, për te përditësuar statusin aktual te laboratorëve rajonale te AKU dhe plotësimin e tyre me pajisje”, vijon më tej AKU në përgjigjen e saj.
Ish-Ministri i Bujqësisë, gjatë diskutimeve të buxhetit për vitin 2021, më 28 tetor 2020 në Komisionin Parlamentar të Veprimtarisë Prodhuese, ndryshe nga sa ndodhi në të vërtetë, shpalli si prioritet investimin në Autoritetin Kombëtar të Ushqimir dhe konkretisht në mbështetje laboratorike.
“Në fokusin tonë qëndron ristrukturimi i AKU-së për të krijuar mundësinë që ky institucion të përmbushë me sukses misionin që i ka dhënë ligji dhe të fitojë vitalitetin e institucioneve simotra në vendet europiane. Gjithashtu, do të investohet për blerjen e 5 pajisjeve laboratorike, pajisjeve për trupat e inspektimit si dhe rikonstruksionin ndërtesës së Drejtorisë së Përgjithshme të AKU-së, e cila u dëmtua nga tërmeti i vitit 2019”, deklaroi Bedi Çuçi, ish-Ministër i Bujqësisë para deputetëve.
Bizneset dhe fermerët në kushtet kur laboratorët e AKU nuk janë të akredituar përballen probleme në lidhje me analizat e produkteve. Ndërsa shqetësimi më i madh mbetet analizimi i produkteve ushqimore nga vetë AKU, pasi çdo vit, ky institucion ka për detyrë hartimin dhe me pas analizimin e një plani marrje mostrash në produkte ushqimore, ushqimi për kafshë, produkte të mbrojtjes së bimëve etj.
Ekspertët kërkojnë që investimi në këto laboratorë të bëhet jo vetëm për infrastrukturën por dhe kapacitetet njerëzore dhe ekspertët e tyre. Vetëm në këtë mënyrë do të bëhet i mundur që të respektohen të gjitha hallkat dhe produktet shqiptare të kenë mundësi të certifikohen dhe të ekspertohen në BE. Ata sygjerojnë të studiohet e analizohet situata e laboratorëve në sektorin publik dhe atë privat dhe të propozohen masa për të mundësuar akreditimin e të paktën një laboratori që ti njihen të vlefshme analizat në vendet e BE.
Ky shkrim është pjesë e projektit që mbështetet financiarisht nga Zyra e Mardhënieve me Publikun e Ambasadës së SH.B.A. në Tiranë. Opinionet, gjetjet, konkluzionet dhe rekomandimet e shprehura janë te autor-it/ve dhe nuk përfaqesojnë domosdoshmërisht ato të Departamentit të Shtetit.